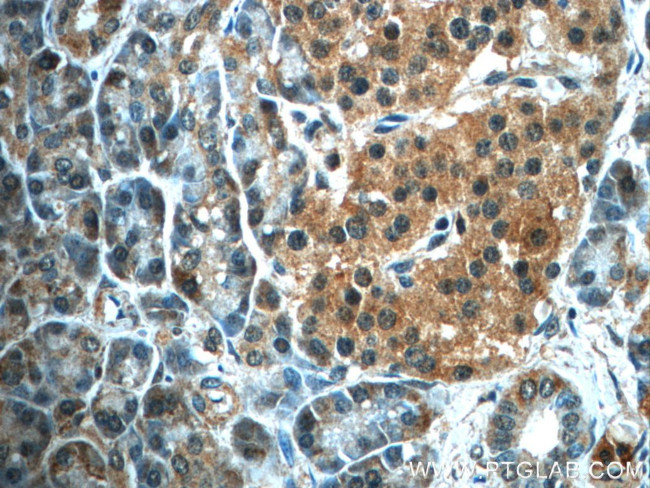
ALDH1L2 Antibody in Immunohistochemistry (Paraffin) (IHC (P))

Search
Proteintech
ALDH1L2 Polyclonal Antibody
{{$productOrderCtrl.translations['antibody.pdp.commerceCard.promotion.promotions']}}
{{$productOrderCtrl.translations['antibody.pdp.commerceCard.promotion.viewpromo']}}
{{$productOrderCtrl.translations['antibody.pdp.commerceCard.promotion.promocode']}}: {{promo.promoCode}} {{promo.promoTitle}} {{promo.promoDescription}}. {{$productOrderCtrl.translations['antibody.pdp.commerceCard.promotion.learnmore']}}
产品信息
21391-1-AP
种属反应
已发表种属
宿主/亚型
分类
类型
抗原
偶联物
形式
浓度
规格
纯化类型
保存液
内含物
保存条件
运输条件
产品详细信息
Immunogen sequence: MVTFYGSTL LNSSVPPGEP LEIKGAKKPG LVTKNGLVLF GNDGKALTVR NLQFEDGKMI PASQYFSTGE TSVVELTAEE VKVAETIKVI WAGILSNVPI IEDS (1-103 aa encoded by BC103935)
靶标信息
This gene encodes a member of both the aldehyde dehydrogenase superfamily and the formyl transferase superfamily. This member is the mitochondrial form of 10-formyltetrahydrofolate dehydrogenase (FDH), which converts 10-formyltetrahydrofolate to tetrahydrofolate and CO2 in an NADP(+)-dependent reaction, and plays an essential role in the distribution of one-carbon groups between the cytosolic and mitochondrial compartments of the cell. Alternatively spliced transcript variants have been found for this gene.
仅用于科研。不用于诊断过程。未经明确授权不得转售。
生物信息学
蛋白别名: 10-formyltetrahydrofolate dehydrogenase ALDH1L2; aldehyde dehydrogenase 1L2; Aldehyde dehydrogenase family 1 member L2; aldehyde dehydrogenase family 1 member L2, mitochondrial; Mitochondrial 10-formyltetrahydrofolate dehydrogenase; Mitochondrial 10-FTHFDH; probable 10-formyltetrahydrofolate dehydrogenase ALDH1L2; unnamed protein product
基因别名: ALDH1L2; D330038I09Rik; mtFDH; RGD1309458
UniProt ID: (Human) Q3SY69, (Mouse) Q8K009
Entrez Gene ID: (Human) 160428, (Rat) 299699, (Mouse) 216188